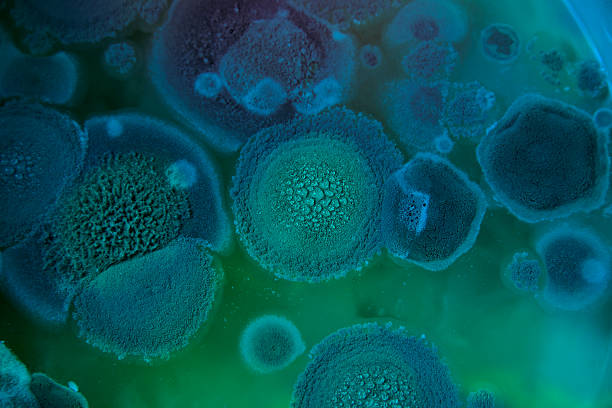

Exploring the Innovative Uses of Microbes in Biotechnology
Biotechnology has emerged as a transformative field that harnesses living organisms to develop new products and technologies that significantly impact various sectors, including medicine, agriculture, and environmental conservation. Among the most revolutionary contributors to biotechnology are microbes, which play a fundamental role in numerous innovative applications due to their diverse metabolic capabilities, rapid growth rates, and ability to thrive in extreme environments. This blog post aims to explore the remarkable and innovative uses of microbes in biotechnology, shedding light on their potential benefits, applications, and the future of this fascinating field.
The Multifaceted World of Microbes
Microbes encompass a wide range of organisms, including bacteria, archaea, fungi, and viruses. While they are often viewed as harmful pathogens, the vast majority of microbes are harmless or beneficial to humans and the environment. In fact, many microbes are indispensable in processes such as nutrient cycling, waste decomposition, and disease control. The unique properties of microbes make them ideal candidates for various biotechnological applications, enabling scientists and researchers to explore their full potential.
One of the primary reasons microbes are indispensable in biotechnological applications is their incredible diversity. With millions of microbial species present in nature, each with distinct metabolic pathways and functions, they can be engineered or utilized in numerous ways to address specific challenges. This versatility plays a critical role in developing effective solutions in healthcare, agriculture, and environmental management.
Microbes in Medicine
When it comes to the medical field, microbes have made significant contributions, particularly in the development of pharmaceuticals and therapies. One of the most notable examples is the use of bacteria in the production of antibiotics. Penicillin, discovered by Alexander Fleming in 1928, was derived from the Penicillium mold and has since saved countless lives by effectively treating bacterial infections. Modern biotechnology has enabled scientists to isolate and genetically modify microbes to enhance antibiotic production, leading to more potent and effective treatments.
Additionally, microbes are instrumental in producing vaccines. For example, yeast and bacteria are utilized in the production of recombinant proteins that serve as antigens, stimulating the immune system to recognize and fight infections. Vaccines for diseases such as hepatitis B and human papillomavirus (HPV) are developed using genetically engineered yeast and bacteria, providing safe and effective ways to prevent serious illnesses.
Advancements in Genetic Engineering
The advent of genetic engineering technologies, such as CRISPR-Cas9, has revolutionized the way scientists manipulate microbial genomes. These advancements allow researchers to make precise alterations to microbial DNA, enhancing desirable traits or enabling new functions. For instance, certain bacteria can be engineered to produce biofuels from waste materials, providing a sustainable alternative to fossil fuels.
This precision in genetic engineering also enables the development of microbes that can produce essential biomolecules, such as amino acids, vitamins, and enzymes, on industrial scales. Such microbial production processes are often more efficient and environmentally friendly than traditional chemical synthesis methods, significantly reducing waste and energy consumption.
Microbes in Agriculture
In the agricultural sector, microbes are increasingly recognized for their vital role in promoting plant health and improving crop yields. Beneficial soil microbes, such as mycorrhizal fungi and rhizobacteria, form symbiotic relationships with plants, enhancing nutrient uptake, disease resistance, and overall growth. These microbial communities are essential for sustainable agriculture, reducing the need for chemical fertilizers and pesticides that can harm the environment.
Moreover, the use of biopesticides, derived from natural microorganisms, offers a safer and more sustainable alternative to chemical pesticides. These biopesticides can target specific pests or pathogens without harming beneficial organisms, thereby promoting biodiversity and ecological balance.

Environmental Applications of Microbes
Microbes also play a crucial role in addressing environmental challenges. Bioremediation, the process of using microbes to detoxify contaminated environments, has gained significant attention in recent years. Bacteria and fungi can break down hazardous substances, such as heavy metals and organic pollutants, transforming them into less harmful compounds.
For example, specific bacterial strains are capable of degrading petroleum hydrocarbons, making them invaluable in cleaning up oil spills. By leveraging the natural abilities of these microbes, scientists have developed effective bioremediation techniques that offer a sustainable solution for environmental cleanup.
Microbiomes: The Future of Biotechnology
The concept of microbiomes—communities of microbes living in association with plants, animals, and humans—has opened new avenues for biotechnological research. Understanding the intricate interactions within microbiomes can provide insights into health, nutrition, and ecosystem dynamics. In human health, research into the gut microbiome has revealed its critical role in digestion, immunity, and even mental health, paving the way for new therapeutic approaches.
In agriculture, harnessing the power of plant microbiomes can enhance crop resilience to stress and disease. By manipulating these microbial communities, scientists aim to develop crops that are not only more productive but also better equipped to withstand changing environmental conditions.
Industrial Applications of Microbes
Microbes have found extensive applications in various industrial processes, particularly in the production of enzymes, which are vital for numerous industries, including food, textiles, and pharmaceuticals. Enzymes produced by microbes, such as amylases and proteases, are essential for breaking down complex substances and facilitating chemical reactions. Their use enhances efficiency and reduces the environmental impact of industrial processes.
For instance, in the food industry, microbial enzymes are employed in brewing, baking, and dairy production, improving product quality and reducing processing times. In biodegradation, enzymes derived from microbes are utilized to break down waste materials, making them essential for sustainable waste management practices.
Ethical Considerations and Safety
Despite the numerous benefits that microbial biotechnology offers, ethical considerations and safety concerns must be addressed. The manipulation of microbial genomes raises questions about potential risks, such as the accidental release of genetically modified organisms into the environment. Moreover, there are concerns regarding biosecurity and the potential for engineered microbes to be misused in bioterrorism.
To mitigate these risks, regulatory frameworks are crucial for overseeing the development and use of microbial biotechnology. Proper guidelines and protocols must be established to ensure the safe handling, containment, and release of genetically modified microbes, prioritizing both safety and ethical standards in biotechnological research.

The Future of Microbial Biotechnology
As research progresses, the future of microbial biotechnology appears promising. Advancements in synthetic biology and metabolic engineering hold immense potential for developing next-generation microbial products and processes. By leveraging the unique properties of microbes, scientists can create tailor-made strains designed to meet specific needs, from producing sustainable fuels to developing new therapeutics.
Moreover, the integration of artificial intelligence and machine learning into microbial research is set to enhance our understanding of microbial behavior and interactions. These technologies can analyze vast amounts of data, revealing patterns that can inform the design of novel microbial systems for various applications, thereby propelling the field of biotechnology forward.
Conclusion
In conclusion, microbes are undeniably at the forefront of innovation in biotechnology, offering a wealth of opportunities for addressing pressing global challenges. Their remarkable versatility, coupled with advancements in genetic engineering and synthetic biology, positions them as valuable tools in medicine, agriculture, environmental remediation, and industry. As we continue to explore the innovative uses of microbes, it is essential to prioritize safety and ethical considerations to ensure the responsible advancement of this exciting field. The potential for microbes to contribute to a more sustainable and healthy future is immense, and their journey in biotechnology is just beginning.
댓글